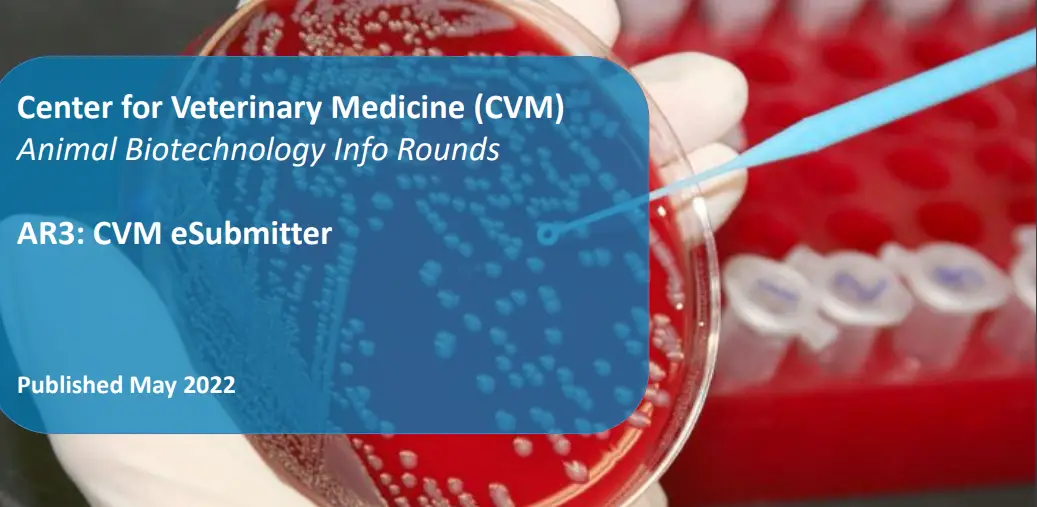
Fda Cvm Esubmitter Master File User Guide

INSTRUCTION MANUAL
Instruction Manual
For instruction and safety information, please read carefully the Instruction Manual or download the PDF version at www.marloxgroup.com/support/manuals
LIMITED WARRANTY
Your ESPRIT watch is guaranteed for 2 years from the date of purchase from an authorized ESPRIT dealer against manufacturing defects. The warranty does not cover the battery, strap, bracelet, crystal, and crown nor does it cover damages arising from normal wear, scratches, lack of care, accidents or misuse, or from any alteration, service, or repair performed by any party other than a ESPRIT service center.
In case of a defect covered by this limited warranty your watch will be repaired or replaced, at the sole choice of the ESPRIT service center, free of charge. Replacement will be with a ESPRIT watch of the same style or a style of comparable value. Any further obligations including liability for incidental, consequential, or special damage and any implied warranties are expressly excluded from this warranty.
The warranty is void if your watch was not purchased from an authorized dealer with a valid warranty card duly stamped and dated by the authorized ESPRIT dealer.
This warranty does not affect any other rights you may have under mandatory statutory law.
AFTER-SALES SERVICE
If your watch requires service, return it to the Authorized Esprit Service center located in your country. A listing of these centers can be found herewith:
www.marloxgroup.com/support/repair_center Please note that for warranty service, the watch to be repaired must be accompanied by the following items:
- The original warranty service card (affixed to the sales information card), or the Sales information card itself (should you prefer to retain your Warranty Card), which has been completed by the Authorized Retailer from whom the watch was purchased.
- The case back of the watch should be legible and not have been manually altered to conceal or destroy any serial numbers or identifying marks that have been placed on the watch during the manufacturing process. The ensure warranty coverage, the Warranty Card must be filled out by an authorized Esprit retailer.

WATER RESISTANCE GUIDELINE
The crown must be in a normal position. The above standards are for guidance only, and water resistance may be affected by misuse, excessive wear and tear, and extreme conditions.
NOTICE
Wristwatches and batteries are not to be disposed into the waste bin.
CE WARRANTY
![]() This product is in con for mity with the provisions of Directive “Electromagnetic compatibility – EMC” (EU – No. 89/336/EEC)
This product is in con for mity with the provisions of Directive “Electromagnetic compatibility – EMC” (EU – No. 89/336/EEC)
ESPRIT Guarantee Information – Download [optimized]
ESPRIT Guarantee Information – Download